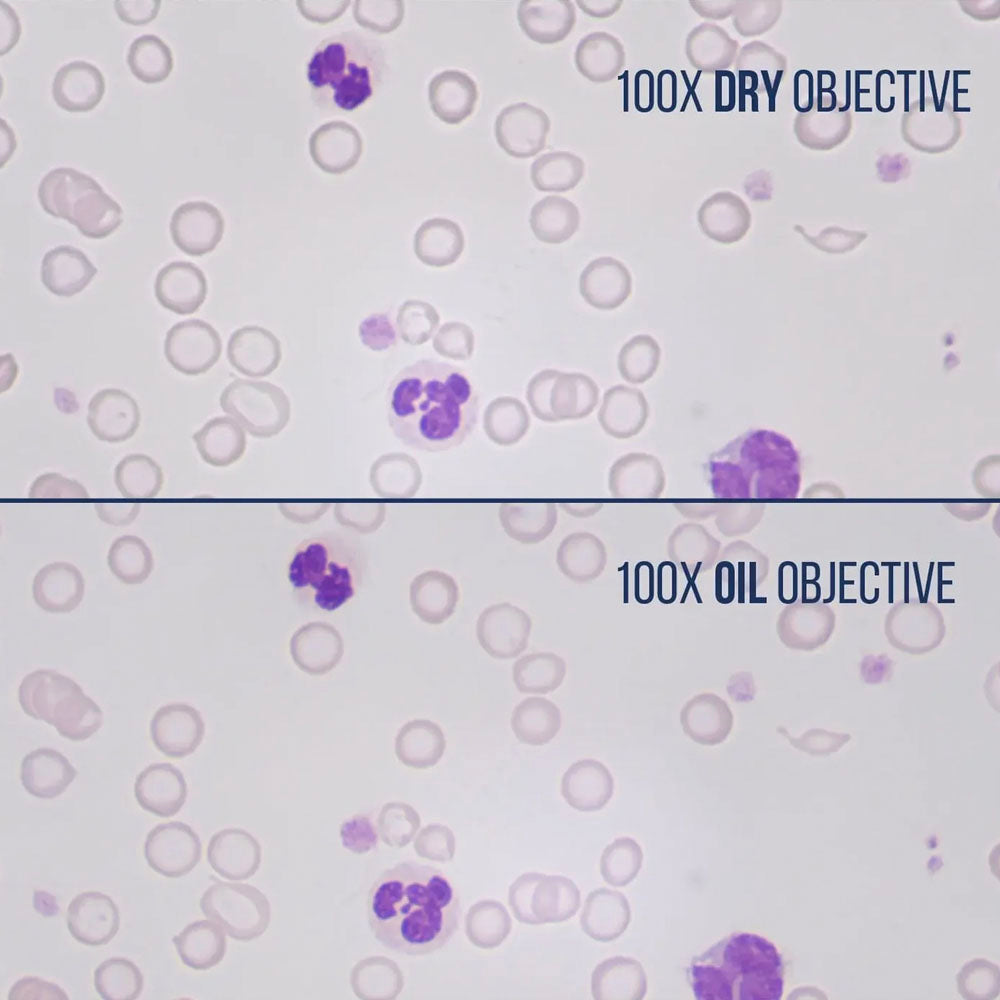
LW Scientific® 100x Magnification Infinity Plan Dry Objective, MSO-100X-IPDR

Estimate shipping
Description
LW Scientific® MSO-100X-IPDR 100x Mag. Infinity Plan Dry Objective for Innovation™/I4™ Microscopes. The new 100x DRY Infinity PLAN objective revolutionizes microscopy with its clarity, resolution, and flat field-of-view, rivaling the best 100x OIL Infinity PLAN objectives. Why use oil?
- Never buy immersion oil again
- Never wipe oil off a slide
- Never clean oil off your fingers or microscope stage
- Never clean oil off the 100x objective
- Never drag a 40x objective through the oil
- Increase efficiency and speed in scanning slides
Imagine the speed and ease with which doctors and techs can now scan cytology slides, free from the hassle of oil.
This objective can be installed on any LW Scientific microscope (i4, Innovation, and Revelation III) and is compatible with other brands like Olympus*, Unico, Motic, Labomed, Swift, Accuscope, and Nikon (with an additional threaded adapter ring, MSP-ADA7-NKOB, required for Nikon e200)
**Does not work with Olympus CX23
Infinity Plan Objective Compatibility Chart for Innovation™/i4™ Microscopes
| Part No | Description | Compatibility |
| MSO-0025-iPDR | 2.5x Infinity Plan Objective | Innovation™/i4™ Microscopes |
| I4O-004X-IPDR | 4x Infinity Plan Objective | Innovation™/i4™ Microscopes |
| I4O-010X-IPDR | 10x Infinity Plan Objective | Innovation™/i4™ Microscopes |
| I4O-020X-IPDR | 20X Infinity Plan Objective | Innovation™/i4™ Microscopes |
| I4O-040X-IPDR | 40x Infinity Plan Objective - WD 0.23 mm | Innovation™/i4™ Microscopes |
| MSO-050X-IPOL | 50x Infinity Plan Oil Objective | Innovation™/i4™ Microscopes |
| MSO-060X-IPDR | 60x Infinity PLAN Dry Objective | Innovation™/i4™ Microscopes |
| I4O-100X-IPOL | 100x Infinity Plan OIL Objective | Innovation™/i4™ Microscopes |
| MSO-100X-IPDR | 100x Infinity Plan DRY Objective | Innovation™/i4™ Microscopes |